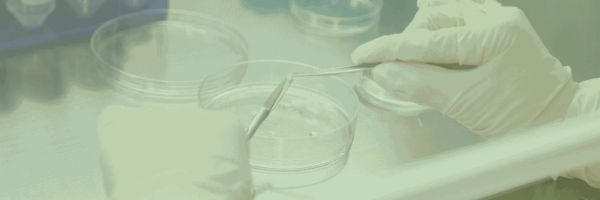

泰盛孕妈小课堂:二胎生产切不可大意,产前知识要清楚
自从国家开放二胎政策以来,越来越多的家庭选择再生一个,选择给家庭再带来一份快乐。但是二胎虽好,也要谨慎对待!不信我们看看下面这个例子!
1月9日,怀二胎9个月的陈女士,白天上班时就出现了隐隐的不规律腹痛,因离预产期还有20多天,她起初并没在意。
当晚8时20分,陈女士出现了30秒一次的规律性腹痛,并且感觉羊水破了,家人一下子慌了神,赶紧拨打了120急救电话。
长沙市第三医院大圫急救分站接到出诊指令后,值班医生曾庆、司机彭应立即出诊,10多分钟就赶到了长沙城南某小区陈女士家中。刚把担架铺好,准备将陈女士抬上救护车赶往医院生产时,陈女士说:“不行不行,我憋不住,应该要生了。”此时躺在沙发上的陈女士惊慌失措,满头大汗,情绪很不稳定。曾庆检查发现,胎儿已经迫不及待露出半个头来,刻不容缓,马上就要生了。
还好曾庆学的是全科医疗,曾接受过相关专业培训,他迅速准备“临时产房”做好接生准备。
“肯定是羊水窒息,呼吸道不畅通。”他判断。于是,来不及多想,曾庆立即用嘴将新生儿口腔、鼻孔里面的羊水一点一点吸出来。吸了几口后,婴儿脸色渐渐红润起来。随着“哇”的一声啼哭,这个着急出来过大年的小宝终于让大家悬着的心放松了下来。
1月11日上午,在医院住院两天后,陈女士和小宝平安回家。

惊险的二胎事件过去之后,陈女士在接受采访时说道:“第一胎的时候痛了两天才生下来,我也查了一些关于生产的知识,以为白天的疼痛是假临产,所以没有着急到医院。没想到这第二胎这么快,小孩的东西都没准备好,搞得我们措手不及。”
有过一次生产经验的孕妈妈再遇到生产问题时,也会被打个措手不及,今天小编就给孕妈妈整理了一些生产知识,一定要熟记于心,可不能像陈女士一样哦~
关键词 1 :见红

临产前,由于不规律的子宫收缩牵动宫颈,使宫颈内口附近的胎膜与子宫壁分离,导致毛细血管断裂,宫颈黏液栓脱落,使血液与宫颈黏液混合在一起从阴道流出,这种现象称为“见红 ”。
提示:见红之后不必过于惊慌赶往医院,因为宫口还未开,不会马上分娩,仅表明产妇可能在1-2 天分娩。
关键词 2 :破水

产妇子宫里的羊膜和绒毛膜紧密连着,形成一个封闭的羊膜囊,囊里有羊水和胎儿。 临产后随着子宫不断地规律性宫缩,胎膜承受到较大的压力刺激,于是发生破裂,使羊水从阴道里流出,这种现象称为“破水 ”。如果产妇在子宫未出现规律性宫缩就发生破水,称为“早破水 ”。
提示:破水后包括早破水,禁止洗浴,产妇先垫上干净的卫生巾和床布,然后躺下,采取臀高位,立即送往医院就诊。
关键词 3: 规律性宫缩

临产前,产妇感到腹部一阵阵发胀、发紧、小腹下坠,这就是宫缩。但在一开始宫缩大多是无规律的,多在夜间出现白天消失,并且持续时间短,间隔时间长。如果宫缩逐渐频繁并增强,两次宫缩的间隔也越来越短,从25 分钟至 1 个小时宫缩一次,持续数分钟,发展到后来间隔2-3 分钟就宫缩一次,持续30 秒左右。同时, 腰痛明显加重,腰骶部出现酸痛,伴随宫缩宫口逐渐开大,胎头下降,这种宫缩称为“规律性宫缩 ”。
提示:如果是初产妇,出现规律性宫缩表明分娩已经开始,应该立即入院准备分娩。
加油,正在努力备孕的准妈妈们!祝愿好孕,生下一个健康的“鼠宝宝”!

特别声明:以上内容(如有图片或视频亦包括在内)为自媒体平台“网易号”用户上传并发布,本平台仅提供信息存储服务。
Notice: The content above (including the pictures and videos if any) is uploaded and posted by a user of NetEase Hao, which is a social media platform and only provides information storage services.
相关知识
【孕前须知】生二胎还要注意这些
“孕妈”知识大课堂
科学孕产:“大龄妈妈”生二胎须知
孕妈课堂
生二胎注意事项 剖宫产后多久可以生二胎
2025华西妇幼健康大讲堂:孕产知识全覆盖,助力妈妈顺利育儿!
孕期小课堂:歌唱胎教好于音乐胎教?
【小迪知识小课堂】产检流程全知道
二胎孕妇要注意些什么
二胎知识 剖腹产后多久可以生二胎
网址: 泰盛孕妈小课堂:二胎生产切不可大意,产前知识要清楚 https://m.trfsz.com/newsview1909392.html